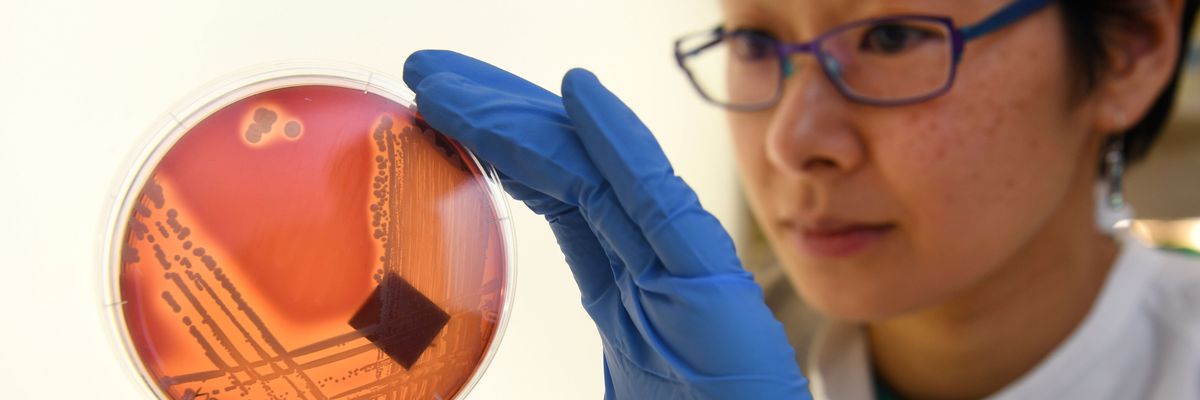

“Each year Americans are at greater risk from dangerous bacteria and diseases because human medicines are sprayed on crops,” one expert said, calling out industry for the “recklessness and preventable suffering.”
Jean Lee, a PhD student at the Doherty Institute, inspects the superbug Staphylococcus epidermidis on an agar plate in Melbourne, Australia.
(Photo by William West/AFP via Getty Images)
Jessica Corbett
Nov 24, 2025
COMMON DREAMS
Just a month after the head of the World Health Organization warned that “antimicrobial resistance is outpacing advances in modern medicine, threatening the health of families worldwide,” a coalition of conservation, farmworker, and public health groups on Monday petitioned the Trump administration to ban the use of crucial drugs as pesticides.
The legal petition provides a list of “active ingredients that are themselves, or whose use can promote cross-resistance to, medically important antibiotics/antifungals,” and requests that the US Environmental Protection Agency (EPA) cancel registrations under the Federal Insecticide, Fungicide, and Rodenticide Act of all products that contain them.
“Research is clear that the use of antibiotics and antifungals as pesticides poses a threat to public health because it contributes to the evolution of pathogens that are resistant to medicine,” the petition states, referring to what are often called “superbugs.”
“Petitioners make this request because of the critical nature of these drugs and drug classes to human and veterinary medicine, along with scientifically established concerns related to increasing resistance and declining efficacy rates as a result of prophylactic and other uses of these antimicrobials outside of the medical field,” the filing continues.
“More than 2.8 million antimicrobial-resistant infections occur in the United States each year, resulting in more than 35,000 deaths.”
Noting that the use of antibiotic pesticides also “directly threatens the well-being of humans and animals through contamination of food supplies and crops,” the filing adds that “petitioners believe that the most effective way to safeguard human and environmental health is to disallow the use of these ingredients in pesticide products.”
The petitioners are the Antibiotic Resistance Action Center at George Washington University, Californians for Pesticide Reform, Center for Environmental Health, Center for Biological Diversity, Center for Food Safety, CRLA Foundation, Friends of the Earth US, Pesticide Action & Agroecology Network, UNI Center for Energy & Environmental Education, and US Public Interest Research Group.
“Each year Americans are at greater risk from dangerous bacteria and diseases because human medicines are sprayed on crops,” said Nathan Donley, environmental health science director at the Center for Biological Diversity, in a statement. “This kind of recklessness and preventable suffering is what happens when the industry has a stranglehold on the EPA’s pesticide-approval process.”
Donley and other campaigners have previously called out the Trump administration for spouting pesticide companies’ talking points in the September Make America Healthy Again report, installing an ex-industry lobbyist in a key EPA post, and doubling down on herbicides including dicamba and atrazine—the latter of which is commonly used on corn, sugarcane, and sorghum in the United States, and last week was labeled probably carcinogenic to humans by a WHO agency.
Underscoring the urgent need for EPA action, the new petition highlights that “more than 2.8 million antimicrobial-resistant infections occur in the United States each year, resulting in more than 35,000 deaths,” according to a 2019 report from the US Centers for Disease Control and Prevention (CDC).
Citing another CDC report, the filing points out that “the Covid-19 pandemic only exacerbated the issue due to longer hospital stays and increased inappropriate antibiotic use, leading to an upsurge in the number of bacterial antibiotic-resistant hospital-onset infections by 20%.”
Globally, antimicrobial resistance “has increased in 40% of the pathogen-antibiotic combinations monitored for global temporal trends between 2018 and 2023, with annual relative increases ranging from 5% to 15%,” according to the WHO analysis released last month. By the end of that period, “approximately 1 in 6 laboratory-confirmed bacterial infections worldwide were caused by bacteria resistant to antibiotics.”
WHO Director-General Tedros Adhanom Ghebreyesus stressed that “we must use antibiotics responsibly, and make sure everyone has access to the right medicines, quality-assured diagnostics, and vaccines. Our future also depends on strengthening systems to prevent, diagnose, and treat infections and on innovating with next-generation antibiotics and rapid point-of-care molecular tests.”
No comments:
Post a Comment